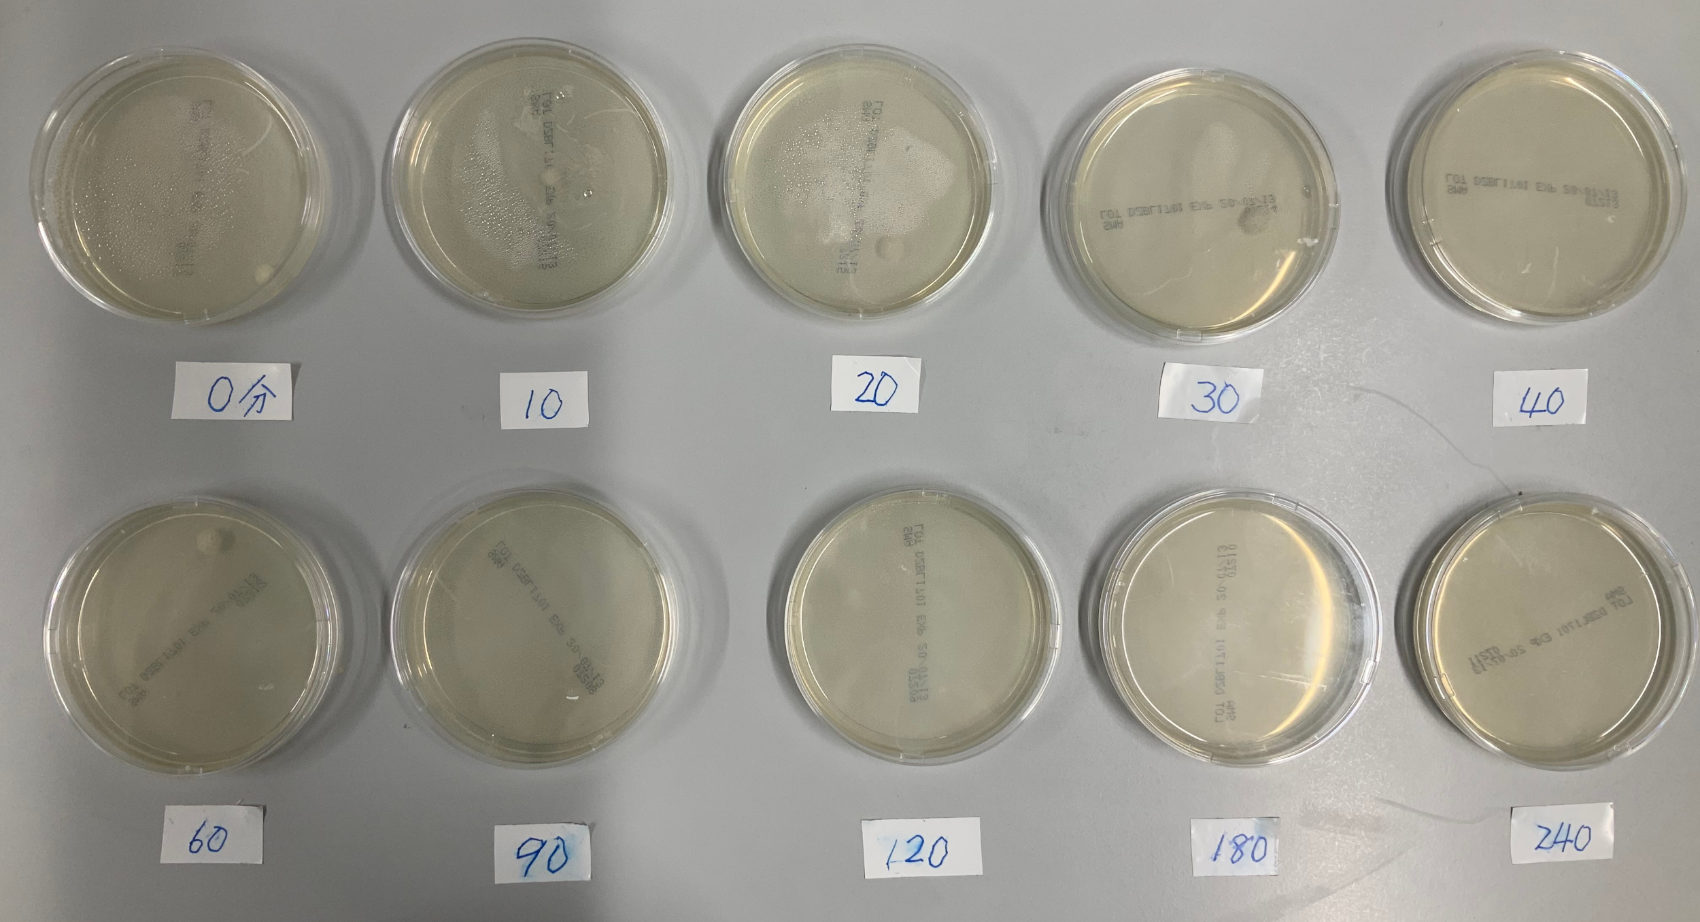
実験風景
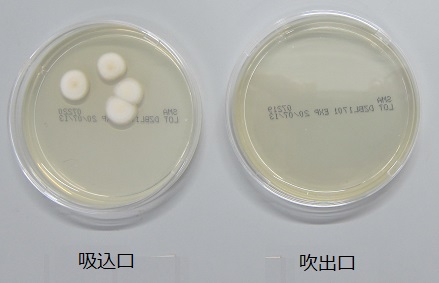
実験風景

通常、空気清浄機などの除菌効果を示すデータは、密閉されたチャンバー内に菌を放出させ、その後、装置を動かして空気処理を行い採取します。しかし、このような方法では、実際の住環境中での空気の除菌性能を正確に評価できません。たとえば、室内で人が動くとき、体に付着した菌が外れ、空気を汚染することが考えられます。
そこで、実際に⼈がいる住空間を想定し、50m3の部屋で1人の人間が活動している場での空気を当社の空気浄化装置ZEROで処理し、菌数がどのように変化するかを観察しました。設定時間ごとに、捕集器にセットしたシャーレ中の寒天培地へ高速で1分間室内空気を当て、捕集を行いました。このとき、室内空気は扇風機で常に混合しました。
実験結果を下の図に示します。0分のとき、10個のコロニーが現れました。10、20、30分の経過とともに菌数は着実に減り、1個になりました。60分後に4個まで増えましたが、その後は着実に減り、0~1個の小さな値となりました。突如として数が増えたり、減ったりする原因として、室内に仕事をしながらサンプリングを行う実験者がおり、時折移動するときに実験者に付着した菌が脱着したり、家具などの陰でよどみ、まだ処理されていなかった空気が動き出したりし、ZEROで処理される前に菌が捕集されてしまったことが考えられます。
捕集された5種類の菌のコロニーは次のようでした。
初期状態はこれらがすべて現れたが、10分後には2,3がなくなり、90分以降には1もなくなりました。

ZEROはターボモード(⾵量5m3/min)で運転しており、この値で部屋の空気体積(50m3)を割ると10分という値を得ます。この値はすべての空気が装置を通過するのに必要な時間ですが、実際には部屋の隅の空気のよどみを考慮する必要があり、その3倍、すなわち30分程度の時間が必要です。このことは、実験開始から20~30分後までに菌数が着実に少なくなっていることに表れています。 この実験結果より、室内の空気中を浮遊する菌は意外に少ないことがわかります。菌は空気より重いため、すぐに沈降し、物などに付着して存在していると推測されます。また、人などの移動により空気の動きがあると、付着した菌が脱離し、再び浮遊してしまうと考えられます 。
上述の実験では、人の存在により菌数が長時間経過してもゼロになりま せんでした。しかし、8 本の UV ランプを一つずつ 8 本の管に挿入した 狭い空間に空気を流して行う、ZERO の強力な除菌原理を考えると、満 足できる結果ではありません。そこで、ZERO の吸込口と吹出口付近で 菌の捕集実験を行いました。このとき、吸込口ではシャーレの向きを調 節して ZERO へ吸引される室内空気ができるだけ寒天培地に当たるよう にし、また吹出口では ZERO を通って勢いよく出てくる空気を直接培地 に当てて 1 分間、菌捕集を試みました。その結果、吸込口の培地にはい くつかのコロニーが表れましたが、吹出口の培地には皆無でした。この ことから、ZERO を通過する空気は瞬時に除菌されており、本装置の除 菌性能の高さが明らかです。